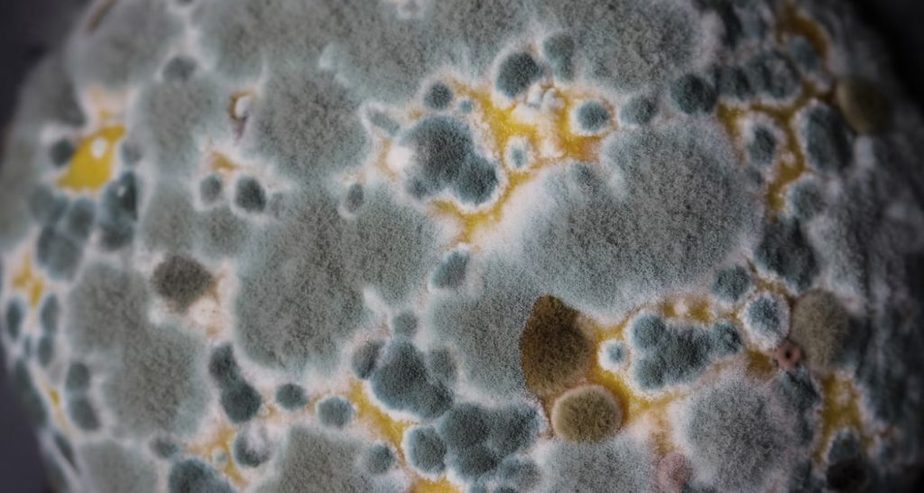
Mattress Mould Vs. Mildew

Before we tackle the ‘how to dry a mattress,’ let’s first be clear on 'why we need to dry a mattress'. Essentially, damp mattresses can be the ideal habitat for various organisms that don’t make ideal sleeping partners. Bacteria, fungi, scabies, and dust mites thrive in damp or humid environments and whilst some may not pose a serious threat, others may result in potentially serious health issues.
The Dangers Of A Wet Mattress
Mattress mould is one of the most common issues associated with wet mattresses and is worth mentioning as it could pose a serious health issue to some. Furthermore, it can be hazardous as many people don’t realise their symptoms are caused by mould exposure.
Not so fun fact!
Britain, in particular, is known for having a ‘damp problem’ and issues with mould - this is largely due to a combination of old housing, damaging building practices and, of course, the weather.
Mattress Mould Vs. Mildew
If you’ve done any research on drying a wet mattress, you’ve most likely come across the mention of mould or mildew. Although these terms are often used interchangeably, there are a few differences (tabulated below) between them, and it’s helpful to be aware of this so that you know what you’re dealing with.
| Characteristic | Mould | Mildew |
| Appearance | ☐ Can appear fuzzy or slimy and can be many different colours, including black, white, grey, blue, green, brown, or yellow. | ○ Mildew has a powdery or downy texture -usually white or yellow when it begins and gradually turns black or brown as it ages. |
| Preferred environment | ☐ Mould is found naturally outside, but spores can be carried inside - it likes warmth, darkness, oxygen, and moisture. | ○ Mildew tends to grow on flat, moist surfaces (often seen on shower walls). |
| Effects | ☐ Exposure to mould can cause a host of respiratory issues✓ - from symptoms of respiratory allergies like sneezing or a runny nose to coughing, wheezing, and shortness of breath. Sufferers of chronic lung illnesses may develop lung infections. | ○ It can pose health risks but not to the extent that mould can - it mostly causes cosmetic damage in the home. |
| Removal | ☐ Mould can grow deep into a mattress and is, therefore, more difficult to remove. If the mould has spread across and through the mattress, it may not be salvageable. | ○ Easier to remove as it only grows on the surface of your mattress. |
Did you know?
In nature, moulds are extremely important as they break down and digest organic material✓ - necessary in all ecosystems.
Different Stain Types
There are many reasons why a mattress could be wet and need drying - from spilling a glass of water, bedwetting to nose bleeds or night sweats. If the mattress is wet due to a water spill or rain through an open window, you can get straight to the drying. However, if you have a blood or urine stain, you will need to tend to this first.
The stain removal method will entirely depend on what type of stain it is. For example, stains can be classed as oil-based or protein-based, amongst several others. So, removing blood from a mattress or urine from a mattress may require a different technique to removing sweat stains or fruit juice.
Once you’ve dealt with the stain accordingly, you will need to dry the mattress.
Techniques To Dry A Mattress
The following techniques can be used to dry a mattress - you might find some more effective than others, or you may need to combine a few methods depending on the extent of the wetness.
- Remove all the bedding as soon as possible (to reduce chances of liquid soaking through to the mattress) and wash it separately.
- Treat any stains, as discussed above.
- For small spots, use a hairdryer - best to use the warm, not hot setting and keep the hairdryer moving.
- Use a wet/dry vacuum to soak up the liquid - be sure to clean the vacuum nozzle first.
- Press clean kitty litter into the mattress to absorb any liquid - cover with a towel and allow to sit, then vacuum with a wet/dry vacuum.
- Sprinkle bicarbonate of soda/baking soda on the mattress - any moisture will be absorbed and odours removed.
Always use a wet/dry vacuum for soaking up liquids, as a regular household vacuum may break or even give you an electrical shock.
Tips For Mattress Drying
In addition to the above techniques, a few useful tips listed below can further facilitate mattress drying - regardless of the reason for wetness or method used to dry.
- Place your mattress in direct sunlight, if possible.
- Provide as much air circulation as possible - open doors and windows or use a fan.
- Be patient - wait until the mattress is completely dry before putting on any bedding.
Tips To Keep A Mattress Dry
Whether you have a brand new mattress or a newly dried mattress, the tips below are well worth remembering to keep your mattress happy and healthy - prevention is always better than cure!
- Use a waterproof mattress protector.
- Pull back the bedding regularly and leave the mattress exposed to fresh air.
- Keep your bedroom as ventilated as possible - let air and sunlight in as much as possible.
- Only put clean bedding on once it is completely dry.
Conclusion
A wet mattress can be a breeding ground for all sorts of unwanted bed guests; however, if your mattress is not beyond help, there are several techniques to dry it effectively. Depending on the extent of the ‘accident’, you may need to repeat or combine several methods - whatever best suits your needs. And, as with stain removal, the quicker you tend to the problem, the easier/more successful you will be.
Frequently Asked Questions
How to get urine out of a mattress when dry?
A dried urine stain should be treated in the same way as you would treat a fresh urine stain - with the correct stain remover for urine (a protein-based stain). Drying methods include using a hairdryer, a wet/dry vacuum, kitty litter or bicarbonate of soda - sunlight and air circulation will always further facilitate drying.
How to dry a mattress?
Mattress drying techniques include using a hairdryer, a wet/dry vacuum, kitty litter or bicarbonate of soda, sunlight and air circulation - a combination of methods may be required depending on the extent of the wetness.
How to dry a mattress after bedwetting?
A urine stain should first be treated as quickly as possible with the correct stain remover for a protein-based stain. Drying methods include using a hairdryer, a wet/dry vacuum, kitty litter or bicarbonate of soda, sunlight and air circulation - a combination of methods may be required depending on the extent of the bedwetting.